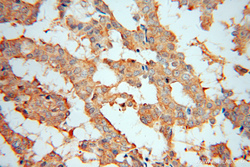

Antibody data
- Antibody Data
- Antigen structure
- References [4]
- Comments [0]
- Validations
- Western blot [1]
- Immunocytochemistry [1]
- Immunohistochemistry [2]
Submit
Validation data
Reference
Comment
Report error
- Product number
- 15348-1-AP - Provider product page

- Provider
- Proteintech Group
- Proper citation
- Proteintech Cat#15348-1-AP, RRID:AB_2156602
- Product name
- PA2G4 antibody
- Antibody type
- Polyclonal
- Description
- KD/KO validated PA2G4 antibody (Cat. #15348-1-AP) is a rabbit polyclonal antibody that shows reactivity with human, mouse, rat and has been validated for the following applications: FC, IF, IHC, IP, WB,ELISA.
- Reactivity
- Human, Mouse, Rat
- Host
- Rabbit
- Conjugate
- Unconjugated
- Isotype
- IgG
- Vial size
- 20ul, 150ul
Submitted references Selective ribosome profiling as a tool to study interactions of translating ribosomes in mammalian cells.
Proliferation-associated 2G4 P48 is stabilized by malignant T-cell amplified sequence 1 and promotes the proliferation of head and neck squamous cell carcinoma.
Evidence for a fragile X messenger ribonucleoprotein 1 (FMR1) mRNA gain-of-function toxicity mechanism contributing to the pathogenesis of fragile X-associated premature ovarian insufficiency.
PA2G4 promotes the metastasis of hepatocellular carcinoma by stabilizing FYN mRNA in a YTHDF2-dependent manner.
Günnigmann M, Koubek J, Kramer G, Bukau B
Methods in enzymology 2023;684:1-38
Methods in enzymology 2023;684:1-38
Proliferation-associated 2G4 P48 is stabilized by malignant T-cell amplified sequence 1 and promotes the proliferation of head and neck squamous cell carcinoma.
Sun L, Xing G, Wang W, Ma X, Bu X
Journal of dental sciences 2023 Oct;18(4):1588-1597
Journal of dental sciences 2023 Oct;18(4):1588-1597
Evidence for a fragile X messenger ribonucleoprotein 1 (FMR1) mRNA gain-of-function toxicity mechanism contributing to the pathogenesis of fragile X-associated premature ovarian insufficiency.
Rosario R, Stewart HL, Choudhury NR, Michlewski G, Charlet-Berguerand N, Anderson RA
FASEB journal : official publication of the Federation of American Societies for Experimental Biology 2022 Nov;36(11):e22612
FASEB journal : official publication of the Federation of American Societies for Experimental Biology 2022 Nov;36(11):e22612
PA2G4 promotes the metastasis of hepatocellular carcinoma by stabilizing FYN mRNA in a YTHDF2-dependent manner.
Sun S, Liu Y, Zhou M, Wen J, Xue L, Han S, Liang J, Wang Y, Wei Y, Yu J, Long X, Chen X, Liang H, Huang Z, Zhang B
Cell & bioscience 2022 May 7;12(1):55
Cell & bioscience 2022 May 7;12(1):55
No comments: Submit comment
Supportive validation
- Submitted by
- Proteintech Group (provider)
- Main image

- Experimental details
- Jurkat cells were subjected to SDS PAGE followed by western blot with 15348-1-AP(PA2G4 antibody) at dilution of 1:2000
- Sample type
- cell line
Supportive validation
- Submitted by
- Proteintech Group (provider)
- Main image

- Experimental details
- Immunofluorescent analysis of MCF-7 cells, using PA2G4 antibody 15348-1-AP at 1:25 dilution and Rhodamine-labeled goat anti-rabbit IgG (red).
- Sample type
- cell line
Supportive validation
- Submitted by
- Proteintech Group (provider)
- Main image

- Experimental details
- Immunohistochemical of paraffin-embedded human breast cancer using 15348-1-AP(PA2G4 antibody) at dilution of 1:100 (under 10x lens)
- Sample type
- tissue
- Submitted by
- Proteintech Group (provider)
- Main image
- Experimental details
- Immunohistochemical of paraffin-embedded human breast cancer using 15348-1-AP(PA2G4 antibody) at dilution of 1:100 (under 40x lens)
- Sample type
- tissue